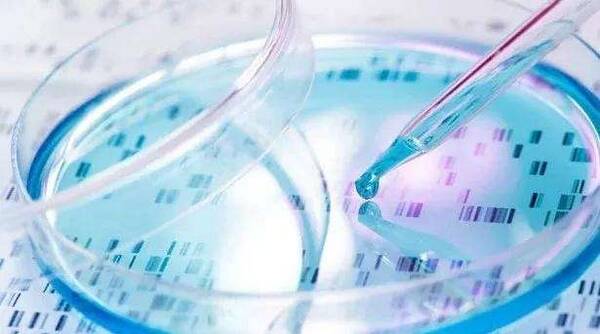
试管婴儿保险 人寿有试管婴儿险?

泰国试管婴儿医院
1082x697 - 175KB - JPEG

泰国第三代试管婴儿成功率有多少呢 一起来了解一下吧
680x425 - 41KB - JPEG

试管婴儿多少钱?孕旅海外自助服务平台为你揭秘
580x324 - 268KB - PNG

泰国试管婴儿成功率多少
484x300 - 140KB - JPEG

去泰国做试管,你需不需要冷冻胚胎?
750x1000 - 74KB - JPEG
第三代泰国试管婴儿优势在哪里?
640x450 - 31KB - JPEG

泰国试管婴儿基因诊断会伤害胚胎吗?
500x321 - 50KB - JPEG

泰国第三代试管婴儿攻略-搜狐
500x332 - 74KB - JPEG
分享去泰国做第三代试管婴儿经历
500x332 - 28KB - JPEG

【讲座】泰国试管婴儿讲座火爆来袭! -河南头条网
576x430 - 41KB - JPEG

泰国试管婴儿一个周期的治疗流程:-搜狐
582x413 - 315KB - PNG

泰国试管婴儿技术成功率高的原因|_综合资讯_青年网
351x221 - 171KB - PNG
试管婴儿保险 人寿有试管婴儿险?
600x334 - 28KB - JPEG

为什么她们做泰国试管婴儿成功率那么高?_育儿频道_东方头条
497x365 - 294KB - PNG

泰国辅助生殖-试管婴儿IVF-搜狐
600x409 - 83KB - JPEG
有关“泰国第三代试管婴儿的费用是如何的”的内容说了这么多,希望能够帮助到大家。泰东方与泰国BNH医院、泰国威它尼医院、泰国EK国际医院
泰国第三代试管婴儿过程中,通过促排卵获得多个卵子,在实验室里与精子结合,形成受精卵,受精卵在实验室里合适的体外环境中进行培养,当受精卵发
试管婴儿成功率以及价格:中国在30%(5--7万),泰国在65%左右(均价13--20万),美国在40%-75%左右(25万-40万) 1,泰国斯蒂文有权威的医生和最新的试管婴儿技术,可以选男选女
提前在当地医院做好身体检查,有拿到报告后可以给泰国医生做个评估,然后确定下了试管方案后,接下来就是赴泰的准备工作,包括签证、飞行这些,到当地的吃住问题,然后过去,见医生后,开始促排、取卵、胚胎培养和移植,最后就是等待验孕了。 基本上的大致流程就是这样,请参考。
其中最吸引不孕不育患者们的便是第三代试管婴儿技术的成功率。目前来说在世界上拥有最高成功率的是美国,其次便是泰国等一些国家,泰国试管婴儿
做试管婴儿帮助很多家庭圆了生儿育女的梦,做试管婴儿注意事项那么多,有哪些是大家经常会问到的呢?那么下面一起来看看,降低泰国第三代试管婴儿
医疗开支大概8-10万,在医院里面做一项交一项。到泰国的生活花费看个人吧,不同。总体价格,依我的经验来看,需预15-18万。
泰国第三代试管婴儿的成功率高达80%,此成功率可以和美国媲美,很多人会以为这只是一个虚拟的数据,没有办法在个体身上真正的实现,所以也未觉得有什么参考价值,但是让贝
泰国第三代试管婴儿技术是指在传统一代和二代试管婴儿技术的基础上,应用胚胎植入前的基因检测或诊断(PDG/PGS)技术。泰国第三代试管婴儿的优势在于可以精确地筛选出